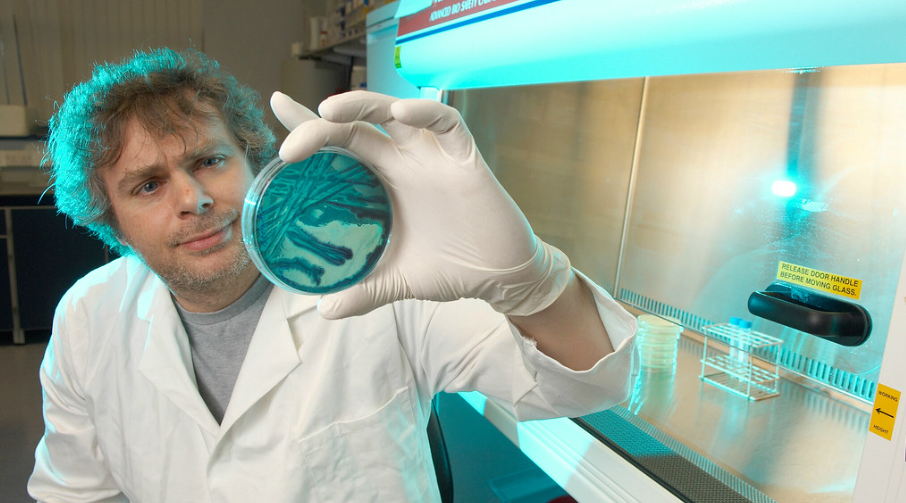
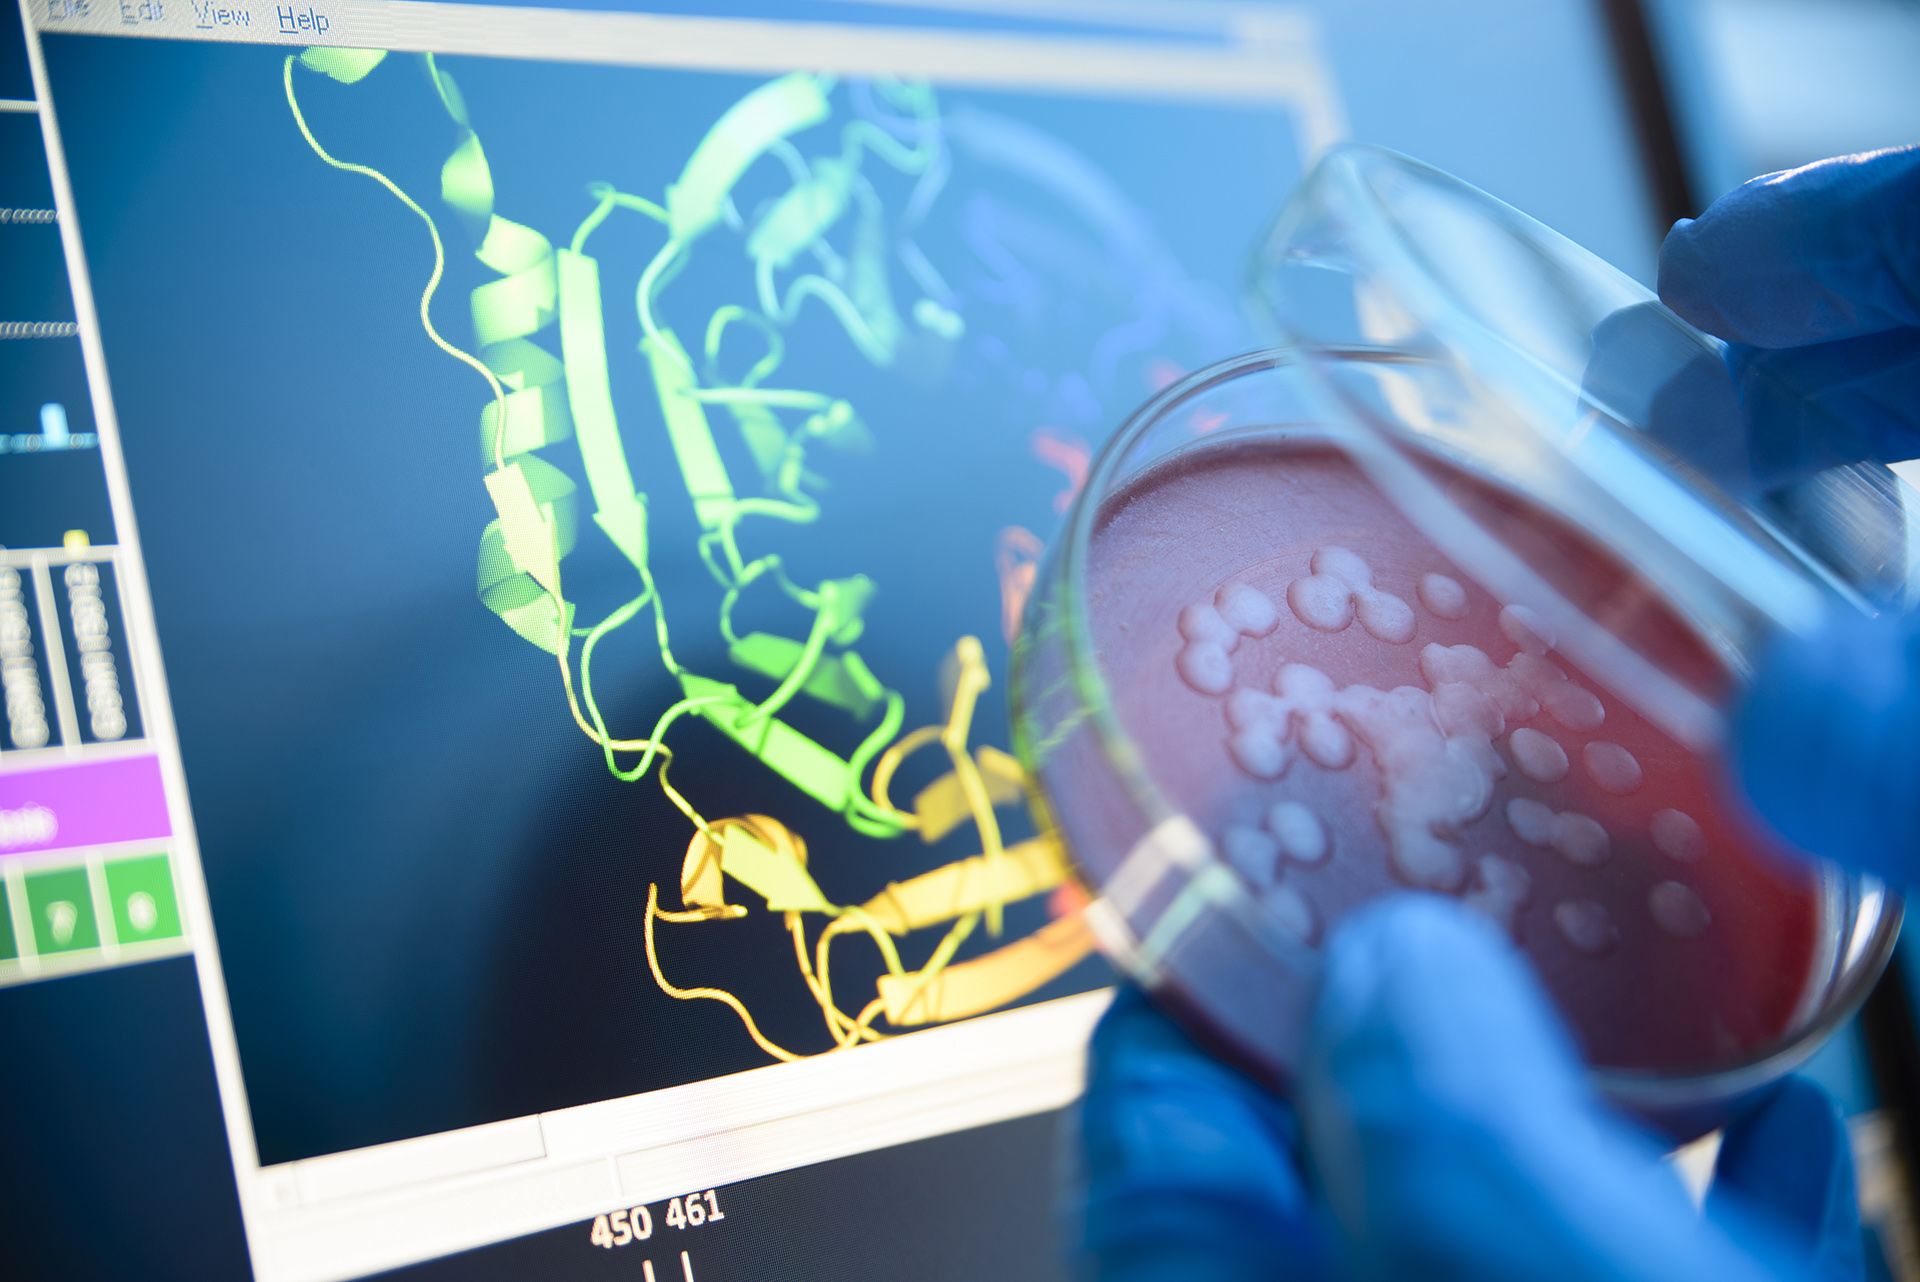

1. Rapid DNA-sequencing system to fight superbugs

- Developed in the UK by Medicines and Healthcare products Regulatory Agency (MHRA) and Barts Health NHS Trust. (The Guardian)
- The system can diagnose bacterial infections and determine antibiotic-susceptibility within 48 hours, compared with up to 7 days (or even 8 weeks) using traditional methods. (The Guardian)
- Trialled on ~2,000 NHS patients, showing strong promise. (The Guardian)
- Impact: Could significantly reduce use of broad-spectrum antibiotics, slow antibiotic‐resistance emergence, speed up correct treatment and reduce complications like sepsis.
- Comment: As one researcher put it:
“By identifying bacteria quickly … we can administer the correct targeted antibiotics sooner.” (The Guardian)
2. UK Biobank/AI proteomics initiative for disease treatment






- A major project announced in 2025 where the UK Biobank and 14 pharmaceutical companies aim to use AI to analyse the proteome (proteins produced by genes) in half a million participants + follow-up samples. (Financial Times)
- Pilot results: over 10,000 new genetic-protein links discovered — improving ability to predict diseases and develop targeted treatments. (Financial Times)
- Impact: Moves beyond genomics into proteomics — giving a deeper understanding of biology; could lead to personalised medicine, better diagnostics, treatments for cancer, autoimmune disease, dementia.
- Comment: This work illustrates that “advanced computers and artificial intelligence models … can harness big biological data sets” to open up previously inaccessible insights. (Financial Times)
3. AI-driven materials discovery tool for clean energy, transport and infrastructure






- A UK spin-out (Polaron) emerging from Imperial College London has developed an AI tool that dramatically speeds up materials development (for example for wind turbines and electric car batteries) from years to days. (The Standard)
- The UK Government awarded £1 million in funding to advance the work. (The Standard)
- Impact: Accelerates the transition to net-zero, enables lighter/stronger components, could lower cost and time of materials innovation.
- Comment: According to the Technology Secretary: “The technology will help the Government meet its net-zero targets.” (The Standard)
4. Direct detection of magnons in a crystal — advancing microscopy & next-gen devices






- UK researchers (including University of York, Durham University and the SuperSTEM facility) succeeded in experimentally detecting and mapping magnons (quantised spin waves) at the atomic scale in a nickel oxide crystal. (Durham University)
- This had been predicted theoretically, but not proven experimentally at such resolution before. (Durham University)
- Impact: Fundamental step for next-gen spintronics, ultra-fast devices, could help miniaturisation of electronics, new paradigms beyond charge-based devices.
- Comment: As one senior scientist said: “a major leap for electron microscopy … a world-first.” (Durham University)
5. New 3D bioprinter for human-like tissues to speed drug discovery






- At Newcastle University, UK scientists developed a new 3D bioprinter (called “ReJI” — Reactive Jet Impingement) which can produce human-like tissues (cell-filled gels) for drug discovery. (News-Medical)
- A spin-out called Jetbio has been created to commercialise this technology. (News-Medical)
- Impact: More realistic tissue models reduce reliance on animal testing, speed up drug development, enable better screening of compounds for diseases like cancer, heart-disease, arthritis.
- Comment: From the report: “holds the potential to revolutionise the discovery of new drugs for cancer, heart disease and arthritis.” (News-Medical)
6. UK to become world-leader in AI-driven drug discovery via the “OpenBind” consortium






- The UK Government announced that the UK would become a world leader in AI-driven drug discovery via a new consortium called OpenBind. (GOV.UK)
- It will generate the world’s largest dataset on how drugs interact with proteins — 20 × greater than anything collected in the last 50 years. Held at the facility at Diamond Light Source in Oxfordshire. (GOV.UK)
- Impact: Huge step for medicines, enzyme design, tackling previously untreatable diseases, also potentially plastic-waste tackling enzymes (not just health).
- Comment: The release states the aim is to “slashing development costs by up to £100 billion” for new drugs. (GOV.UK)
7. New technologies to boost health, farming and food-security

- The Biotechnology and Biological Sciences Research Council (BBSRC) announced 31 new awards (£27 million) in September 2025 for technologies in health, farming, food-security. (UK Research and Innovation)
- Example: At University of Exeter a “Global Meteorological Simulator” replicates wind, rain, future climate conditions to study how crops & pollinators respond. (ISMB)
- Impact: Helps build resilient agriculture under climate change, improves nutrition/food security, supports health research and sustainable farming systems.
- Comment: Dr Amanda Collis (BBSRC) said these tools will help “answer some of the most pressing challenges in biology and beyond.” (UK Research and Innovation)
- Here are five strong case-studies of major UK scientific breakthroughs in 2025 — each with what was achieved, its potential impact, and some of the commentary around it. If you like, I can pull in five more to make a full “top 10”.
1. Biotech automation via acoustic levitation





- Researchers at University of Bristol (via spin-out Impulsonics Ltd) developed a novel device that uses acoustic levitation — moving cells and particles without physical contact — to automate biomedical tasks on a benchtop scale. (University of Bristol)
- It enables processes such as cell expansion and screening previously done in large equipment, with a much smaller footprint: “half the size of a standard lab bench”. (University of Bristol)
- Impact: Could accelerate drug discovery, personalise medicine screening, and reduce cost/time in labs.
- Commentary: Dr Luke Cox (CEO) noted this “allows the process of screening new drugs to be accelerated… we can help discover new drugs for all kinds of diseases ranging from cancer to Alzheimer’s.” (University of Bristol)
- Why it matters: Automation of cell-biology tasks is a bottleneck. Removing manual handling and large machinery could democratise advanced biotech workflows.
2. Semiconductor breakthrough for next-gen communications






- At University of Bristol, physicists discovered a “latch-effect” in Gallium Nitride (GaN) devices using sub-100 nm fins in structure called SLCFET (Superlattice Castellated Field Effect Transistor). (University of Bristol)
- This unlocks vastly higher radio-frequency device performance (75 GHz–110 GHz) which could underpin 6G, ultra-low latency networks, and high-throughput data transfer. (University of Bristol)
- Impact: Technologies like autonomous vehicles, remote surgery, high-fidelity VR/AR, and massive IoT deployments become more feasible.
- Commentary: Professor Martin Kuball remarked that within the next decade “previously almost unimaginable technologies … could be widely available.” (University of Bristol)
- Why it matters: Hardware breakthroughs underpin future connectivity. UK leadership here positions it well in global tech supply-chains.
3. Cancer-targeting graphene material




- Scientists at Oxford Brookes University developed a new form of few-layer graphene (FLG) via a safe, water-based process (ultrasonic cavitation) which in lab tests destroyed cervical cancer cells while sparing ~90% of healthy cells. (Oxford Brookes University)
- The process is cost-effective (~US$20/gram) and avoids toxic solvents. (Oxford Brookes University)
- Impact: If translated to human therapy, this could lead to more targeted cancer treatments with fewer side-effects, and potentially easier manufacturing.
- Commentary: Dr Amanpreet Kaur said: “This is an important stepping stone toward using graphene in real-world cancer treatments.” (Oxford Brookes University)
- Why it matters: Graphene has been touted for medicine but safety/scale challenges held it back; this addresses those directly.
4. Control of molecular chirality for improved cancer drugs




- Researchers at University of Bristol led by Professor Varinder Aggarwal discovered a new mechanism to switch the handedness (chirality) of certain organic compounds widely used in medicines, including the breast-cancer drug Tamoxifen. (University of Bristol)
- Published in the journal Nature, this changes our understanding of how this class of compounds reacts and opens the door to making safer, more effective variations. (University of Bristol)
- Impact: Could lead to next-generation drug molecules with improved potency and fewer side-effects by precisely controlling molecular form.
- Commentary: Professor Aggarwal said: “The findings change our understanding of the fundamental chemistry of this group of organic molecules.” (University of Bristol)
- Why it matters: Chirality (left-hand/right-hand forms) is critical in pharmacology; being able to flip and control it efficiently enhances medicinal chemistry capabilities.
5. Advanced organ-on-a-chip human tissue models






- At Queen Mary University of London, bioengineers developed new organ-on-a-chip techniques where human cells grow in micro-chips with controlled gradients of growth factors, enabling mimicry of complex tissue interfaces (e.g., bone/cartilage). (Queen Mary University of London)
- Their method works across different human tissues and commercial platforms, enhancing the fidelity of in-vitro models and potentially reducing animal testing. (Queen Mary University of London)
- Impact: Accelerates drug testing, improves disease modelling, may reduce costs and ethical issues associated with animal-based research.
- Commentary: Professor Martin Knight said the research “could help speed up the development of safer, more effective treatments, and reduce our reliance on animal testing.” (Queen Mary University of London)
- Why it matters: Tissue modelling is a key bottleneck in translational medicine — better models mean faster and more reliable drug discovery.
6. Fusion plasma stability via 3D magnetic coils





- Researchers at UK Atomic Energy Authority (UKAEA) achieved the world-first use of 3D magnetic coils to stabilise instabilities in a spherical tokamak plasma. (NucNet)
- This is a major step toward practical fusion energy by improving plasma confinement and stability — one of the core challenges in fusion reactors. (NucNet)
- Impact: Brings the UK and global community closer to viable fusion power — a potential game-changer in clean energy.
- Commentary: The coverage described it as a “major breakthrough for fusion energy research”. (NucNet)
- Why it matters: Fusion promises abundant, low-carbon energy. Progress in stability and control is foundational for commercial rollout.
7. AI-driven drug-discovery consortium (OpenBind)



- The UK government announced the formation of the OpenBind Consortium to drive AI-driven drug discovery: generating the world’s largest dataset of drug-protein interactions (20× larger than in the last 50 years) based at Diamond Light Source in Oxfordshire. (GOV.UK)
- It aims to slash the cost of drug development by up to £100 billion and position the UK as a global hub in AI-driven medicines. (GOV.UK)
- Impact: By combining big-data, AI, and structural biology, new treatments for previously intractable diseases may emerge faster and cheaper.
- Commentary: The government said this “will support the training of new AI models… unlocking new avenues for drugs that can treat and beat diseases.” (GOV.UK)
- Why it matters: Drug discovery is expensive and slow; applying advanced AI and massive datasets can bring transformational change.
Commentary & Larger Themes
- These breakthroughs show the breadth of UK science: from materials (graphene), medical biotech (organ-chips, drug datasets), physics (semiconductors, fusion), automation (acoustic levitation) and more.
- A recurring theme is scale-up and translation: many of the breakthroughs emphasise moving from lab demonstration to real-world application (e.g., drug screening, 6G hardware, fusion energy).
- Also: they highlight UK’s ambition to lead in strategic sectors (AI-driven medicines, quantum/space/6G, clean energy), aligning with government industrial strategy.
- Some challenges remain: Translating these breakthroughs into commercial deployment, securing funding, navigating regulatory/ethical issues, scaling manufacturing, and ensuring global competitiveness.
Why these matter for the world
- Improved health outcomes (targeted cancer therapies, better drug models, AI-driven medicines) affect millions globally.
- Improved connectivity and next-gen hardware (6G, semiconductors) underpin future digital societies, autonomy, smart infrastructure.
- Clean energy breakthroughs (fusion) are vital for fighting climate change and securing sustainable energy for all.
- Automation of biotech and tissue modelling can speed up discovery, reduce cost/time, and reduce animal testing.
- These advances strengthen the UK’s position in the global science & innovation ecosystem and help attract talent/investment.
